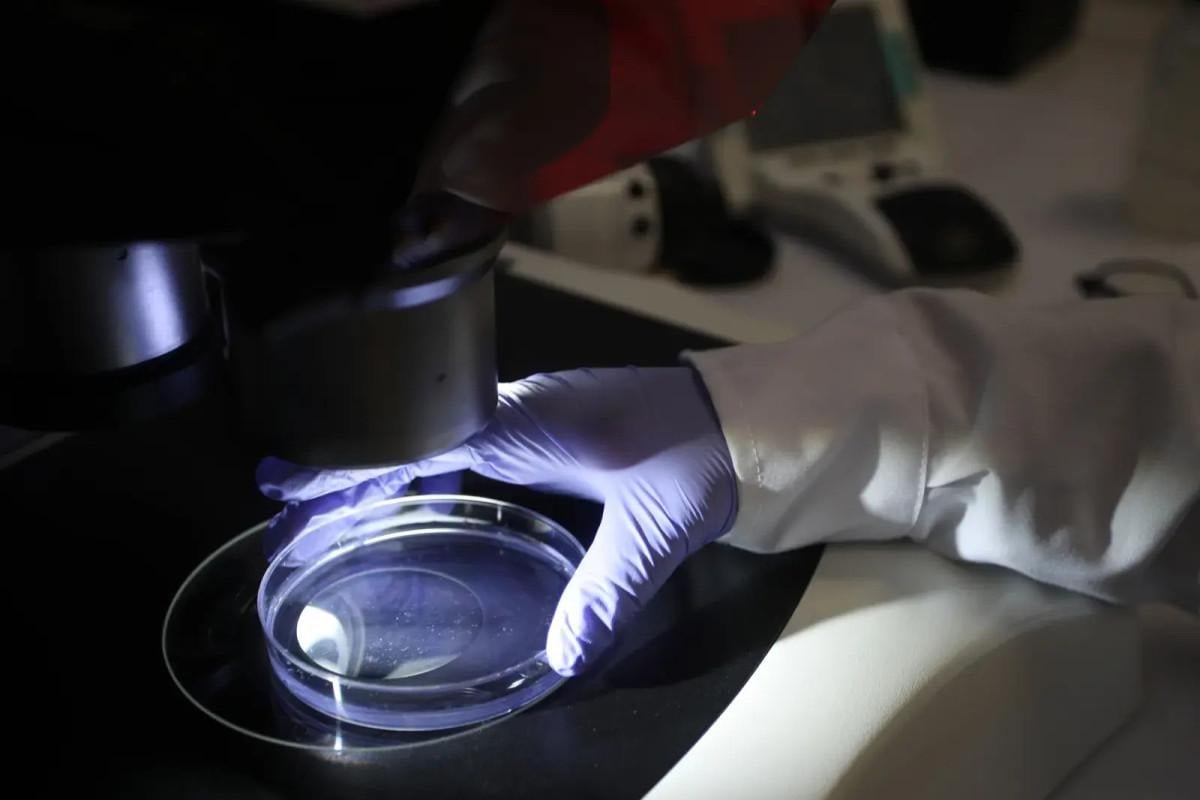

- Araştırmacılar, yapay zeka kullanarak bakterileri başarılı bir şekilde öldüren virüsler tasarladı.
- Bu teknoloji, özellikle tarım ve gen terapisi gibi alanlarda büyük bir potansiyele sahip.
- Ancak uzmanlar, kötü amaçla kullanım riskine karşı dikkatli olunması gerektiği konusunda uyarıyor.
Kaliforniyalı bir şirket, yapay zeka kullanarak sıfırdan virüs genomları tasarladı ve bu tasarımları laboratuvarda üreterek test etti.
Yapay zeka tarafından oluşturulan bu virüslerin, E. coli bakterilerini başarıyla enfekte edip öldürdüğü ve bu durumun üretken modellerin işlevsel genetikler yaratabileceğini kanıtladığı açıklandı.
"TAM GENOMLARIN İLK ÜRETKEN TASARIMI"
Stanford Üniversitesi ve Arc Enstitüsü'ndeki araştırmacılar, ChatGPT benzeri bir yapay zeka modelini yaklaşık 2 milyon bakteriyofaj (bakterileri enfekte eden virüsler) verisiyle eğitti. Ardından yapay zekanın önerdiği 302 yeni genomu laboratuvarda üretti.
Bu tasarımlardan 16 tanesinin, bakterileri çoğaltıp öldürebilen başarılı virüsler oluşturduğu görüldü. Bu, "tam genomların ilk üretken tasarımı" olarak nitelendirildi.
BÜYÜK POTANSİYEL, CİDDİ RİSKLER
Bu teknolojinin, tarımda veya gen terapisinde bakteriyel enfeksiyonlarla mücadele gibi alanlarda büyük bir potansiyele sahip olduğu belirtiliyor.
Ancak genom öncüsü J. Craig Venter, bu alanda "aşırı dikkatli olunması" gerektiği konusunda uyardı.
Venter, "Eğer biri bunu çiçek hastalığı veya şarbonla yapsaydı, çok ciddi endişelerim olurdu." diyerek potansiyel tehlikelere dikkat çekti.
Araştırma ekibi, bu riski önlemek için yapay zekanın eğitiminden insanları enfekte eden virüsleri hariç tuttuklarını belirtti.